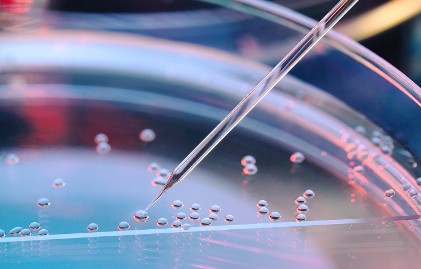
A 2019 Healthcare Market Recap and 2020 Forecast by Mizuho Americas

Healthcare capital markets were in peak form in 2019, after starting the year on a note of uncertainty. Biotech and healthcare stocks soared, led by a crop of IPOs whose performance beat all the market averages. Healthcare companies raised nearly $52 billion in new equity capital for the second year in a row.
Can the favorable momentum continue? The short answer is yes. Here's a rundown of what happened last year, along with our thoughts on what to expect in 2020.
2019 Trends and Highlights: A Strong Year for Healthcare Equity Markets
Healthcare shares soared in 2019, with the NASDAQ Biotechnology Index (NBI) and the XBI S&P Biotech ETF advancing 24.4% and 32.6%, respectively, generally in line with the S&P. At the same time, volatility for the broad market (VIX) and NBI index fell by about half to 12.5, a historic low. Among NBI companies, performance varied greatly by market cap: Those with market caps greater than $10 billion rose 11% on average, while the average gain for $5 billion to $10 billion companies was 25%. In general, the lower the market cap, the higher the gain.
Healthcare equity issuance was robust, bringing in $51.9 billion. the same as in 2018 despite a 9% decline in number of transactions. Of last year’s 282 equity deals, 24% were IPOs that raised $13.8 billion, 61% were follow-on stock issues ($25.5 billion), 10% were convertibles ($8.9 billion) and 5% were block trades ($3.7 billion).

Source: Dealogic, Bloomberg
Healthcare IPOs outperformed all equity market indices in 2019, climbing an average of 46.4%. Two-thirds of last year’s IPOs continue to trade above their issue prices. IPO investors wisely focused on high-value therapeutics that improve care standards and gave less weight to drug pricing and political issues.
The IPO market was open to life-sciences companies across all clinical stages. Early-stage life-sciences companies with promising therapies in development or in Phase 1 trials represented 33% of IPO activity, in line with 2018’s 32%. However, in a reversal of 2018’s pattern, late-stage companies had a higher IPO market share (40%) than intermediate-stage companies (27%) as investors displayed discipline and caution. Parsing IPO activity by therapeutic area, investors favored companies focused on genetically identified diseases and particular cancers over companies that specialize in immuno-oncology, gene editing and gene therapies. Neurological and central nervous system drug developers continued to draw strong investor backing.
Healthcare convertible stock deals raised $8.9 billion in a year when overall convertible issuance reached $55 billion, a post-crisis high. Healthcare companies were the second-most-active issuers of converts, trailing only technology companies.
Looking Ahead to 2020: Four Predictions for Healthcare Capital Markets
The healthcare sector enters the year riding a wave of improved fundamentals, and we expect the momentum to carry over into 2020. Here’s our forecast:
- Last year’s exceptional secondary market performance amid low volatility sets an optimal backdrop for another strong year for the healthcare capital markets.
- Robust demand will continue for IPOs of life-science companies with validated research approaches and encouraging trial outcomes.
- Stock price increases after news of positive clinical results grew more pronounced in 2019, often followed by sustained improvement, as long-only investors crowded into shares. We expect that trend to continue.
- Investors remain hungry for new convertible paper, auguring another good year for companies to tap the convertibles market at very attractive prices.